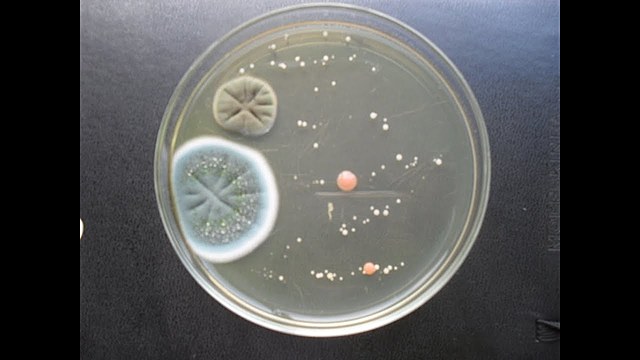
Diseminacion de las esporas de los hongos

-
En 1729, Michelli observó que las partículas de polvo que eran tomadas a partir de un hongo y depositadas en rebanadas de melón recién cortadas, reproducían a menudo la misma clase de hongo. Concluyó que dichas partículas eran las semillas (esporas) del hongo y que los diferentes hongos que a veces aparecían eran producidos por las esporas transportadas en el aire) VELASCO, J. 2013. Hongos perjudiciales para la humanidad (II): hongos parásitos de plantas.
-
Descubrimiento de hongos y otros patógenos como causantes de enfermedades.- Michelli (1729) .- observó que partículas de polvo tomadas de un hongo y depositadas sobre un medio nutritivo (melón) desarrollaban el mismo tipo de hongo Buss Cezar Fontana, M. (2009). Estudio epidemiológico de alergia a hongos y otros neumoalergenos, en estudiantes de medicina de la Universitat Autònoma de Barcelona, con relación a los niveles fúngicos ambientales. Universitat Autònoma de Barcelona.
-
Needhan estudio por primera vez los nematodos (1743) en el interior de agallas de granos de trigo. Fue partidario de la generación espontánea Marbán Mendoza, N. (1987). Quimioterapia en nematodos.
-
1810 epidemia ocasionada por el tizón de la patata en el N de Europa (especialmente Irlanda) estimuló la investigación. DeBary (1861)demostró que el hongo Phytophtora infestans era el causante de la enfermedad Polania Solano, L. J., & Sthing Arias, J. (2015). Evaluación de la producción de peróxido de hidrógeno asociada a respuestas de resistencia en aguacate Persea americana inducida por estrés biótico.
-
1876 Pasteur y Koch descubrieron enfermedades en plantas producidas por bacterias Stanier, R. Y., & Villanueva, J. R. (1996). Microbiología. Reverté.
-
En 1878 se demostró que las bacterias estaban asociadas con el tizón de fuego de las manzanas y peras en Illinois y Nueva York en EEUU (Burril 1878) Vidaver, A. K., & Lambrecht, P. A. (2004). Las bacterias como patógenos vegetales. Trans. Ana María Romero. The Plant Health Instructor. DOI, 10.
-
En 1885, J.C. Arthur aisló una bacteria de plantas enfermas, la cultivó y después inoculó al mismo hospedante para reproducir una enfermedad que ocurría naturalmente. Después la recuperó de tejidos enfermos, completando lo que se conoce como los postulados de Koch (Arthur 1885) Vidaver, A. K., & Lambrecht, P. A. (2004). Las bacterias como patógenos vegetales. Trans. Ana María Romero. The Plant Health Instructor. DOI, 10.
-
1886 Mayer inyecta el jugo de plantas infectadas por el “mosaico del tabaco” a otras plantas sanas. Concluye que podría ser una bacteria Biólogo, Q. F. (2012). Libro electrónico de Virología Médica (Doctoral dissertation, UNIVERSIDAD NACIONAL AUTÓNOMA DE MÉXICO).
-
1889 Mayer reprodujo la enfermedad del “mosaico del tabaco”, 12 años después se supo que se trataba de un virus.
-
En 1892 Ivanowski demuestra que el agente que provoca el “mosaico del tabaco” puede pasar a través de un filtro que retiene las bacterias.
-
Beijerinck en 1898 concluye que el mosaico del tabaco es ocasionado por un virus Biólogo, Q. F. (2012). Libro electrónico de Virología Médica (Doctoral dissertation, UNIVERSIDAD NACIONAL AUTÓNOMA DE MÉXICO).
-
El HLB pone en peligro de extinción a los cítricos, por lo que no es descabellado imaginar un mundo sin estas valiosas frutas en la medida en que no aparezca una cura Ploper, D. (2015). Fitopatología y productividad: los desafíos del conocimiento aplicable.
-
Es importante destacar que existen dos variantes de raza 4 de Fusarium oxysporum f. sp. cubense, la raza 4 subtropical (STR4) que ha sido registrada en Islas Canarias, Sudáfrica y Australia, quenecesita de bajas temperaturas y condiciones abióticas que predisponen a la planta para el desarrollo de la enfermedad. La Raza Subtropical 4 (RST4) (Pérez-Vicente et al., 2014).
A list shows items. A timeline shows sequence.
Use Timetoast to make dates, milestones, and turning points easier to understand in a clear visual format. Timetoast is a timeline maker for work, school, research, and stories.